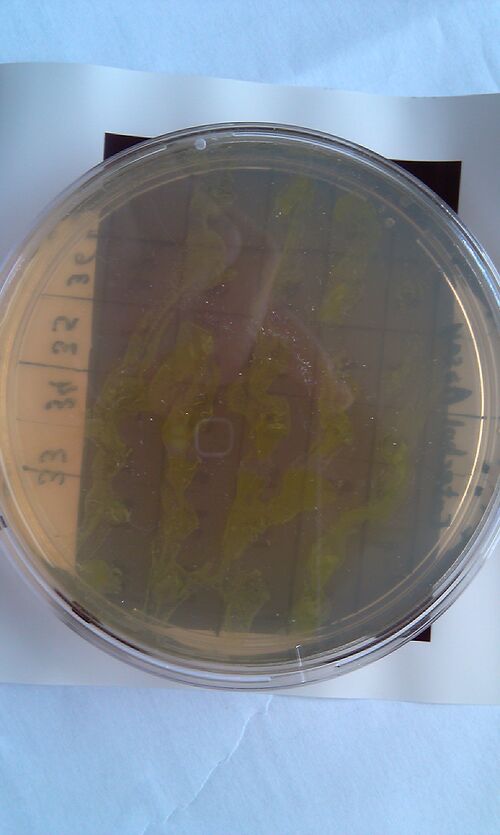
A
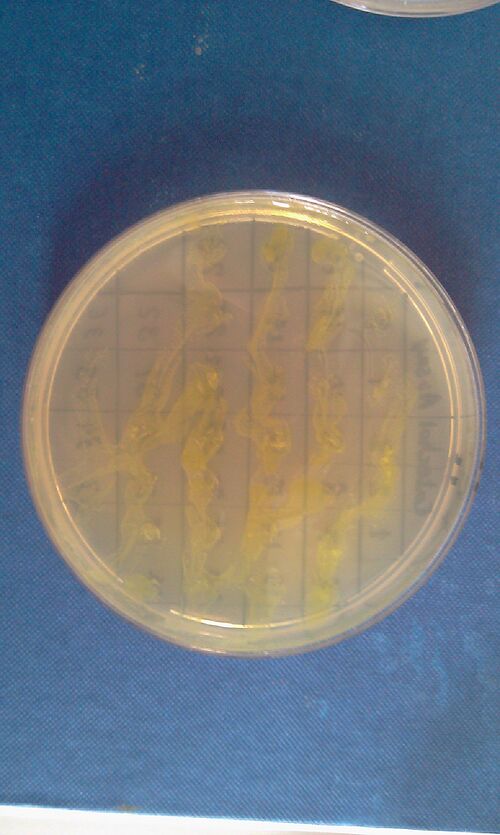
A

IGEM:Imperial/2010/XylE team: Difference between revisions
| Line 218: | Line 218: | ||
*<font color = green>find optimun wavelength for catechol assays</font> | *<font color = green>find optimun wavelength for catechol assays</font> | ||
|| | || | ||
*< | *<font color = green>find optimun cell density and catechol concentration for assay</font> | ||
|| | || | ||
|- | |- | ||
Revision as of 10:05, 6 September 2010
<html>
<head>
<style type="text/css">
- content {background-image: url(http://openwetware.org/images/6/64/Nubgrd.JPG)}
</style> </head> <body> </body> </html>
<html>
<head>
<meta http-equiv="Content-Type" content="text/html; charset=utf-8" /> <title>Imperial iGEM 2010</title> <script type="text/javascript" src="http://ajax.googleapis.com/ajax/libs/jquery/1.4.2/jquery.min.js"></script> <script type="text/javascript"> $(document).ready(function(){ $("ul[id|=poplist]").hide();
$("p[id|=popshow]").click(function() {
$("ul[id|=poplist]").slideToggle("slow");
return false;
});
});
</script>
<style type="text/css">
#popcon
{
width: 360px;
}
#popcon ul
{
margin-left: 0px;
padding-left: 0px;
list-style: none;
font-family: Arial, Helvetica, sans-serif;
}
#popshow
{
width: 360px;
margin-left: 0px;
padding-left: 0px;
list-style: none;
font-family: Arial, Helvetica, sans-serif;
display: block;
color: #CCCCCC;
text-decoration: none;
text-align: center;
background-color: #FFFF66;
padding: 3px;
border-bottom: 1px solid #fff;
}
#popcon a:link, #popcon a:visited
{
display: block;
color: #CCCCCC;
text-decoration: none;
text-align: center;
background-color: #FFFF66;
padding: 3px;
//border-bottom: 1px solid #FFF;
}
#popcon a:hover, #popcon a:active
{
background-color: #FF9966
}
</style>
</head> <body>
Follow our progress: Click me!
- <a href="#Week_6" class="popt">Week 6</a>
- <a href="#Week_7" class="popt">Week 7</a>
- <a href="#Week_8" class="popt">Week 8</a>
- <a href="#Week_9" class="popt">Week 9</a>
- <a href="#Lab_Diary" class="popt">Lab Diary</a>
- <a href="#Output_Photo_Gallery" class="popt">Output Photo Gallery</a>
</body> </html>
XylE team Lab Objectives
- construction of XylE fusion protein
- Testing expression of XylE in E.coli and characterization under the control of a constitutive promoter
- Construction of the -ComE promoter/XylE fussion protein- expression system
- Construction of the -LacI promoter/XylE fusion construct- expression system
Schedule
Week 6
| Week 6 | Monday | Tuesday | Wednesday | Thursday | Friday | Weekend |
|---|---|---|---|---|---|---|
| MORNING |
|
|||||
| lunch break | ||||||
| AFTERNOON |
|
|
Week 7
| Week 7 | Monday | Tuesday | Wednesday | Thursday | Friday | Weekend |
|---|---|---|---|---|---|---|
| MORNING |
|
|
|
|
|
|
| lunch break | ||||||
| AFTERNOON |
|
|
*primers arrived! |
|
Week 8
| Week 6 | Monday | Tuesday | Wednesday | Thursday | Friday | Weekend |
|---|---|---|---|---|---|---|
| MORNING |
|
|
|
|
|
|
| lunch break | ||||||
| AFTERNOON |
|
|
|
|
|
Week 9
| Week 9 | Monday | Tuesday | Wednesday | Thursday | Friday | Weekend |
|---|---|---|---|---|---|---|
| MORNING |
|
|
|
|
|
|
| lunch break | ||||||
| AFTERNOON |
|
|
|
Lab Diary
Thursday, 12-Aug-2010
- anealing DNA strands of J23101 promoter in a waterbath
we constructed the standard E.coli promoter J23101 with sticky ends. These ends are complementary to restriction sites made by EcoRI and SpeI enzyme. This promoter will be later used in 3A assemply to construct a promoter-RBS-XylE design in a psB1C3 vector. E.coli will be transformed with this final construct plasmid to assess XylE activity and characterization. It will also be one of the submitted biobricks.
- prepared two overnight cultures of XylE transormed E.coli (one 50microliters and one of 450 microliters)
these cultures are going to be used tomorrow for mini-prepping. Miniprep will allow us to isolate E.coli's plasmid DNA(which contains the XylE gene).
Friday, 13-Aug-2010
- mini-prep of XylE transformed E.coli
Mini-prep is usually used to confirm that our gene of interest has not been changed in any way, as the isolated plasnid id sent for sequencing. However, since XylE was taken from the registry, we assume that it is fine and no sequencing is required. The mini-prep will later be used for the midi-prep (that gives out higher yeilds of DNA needed for cloning).
- gel analysis of plasmid DNA retreived from mini-prep of XylE transformed E.coli, cut with restriction enzymes. From light to the left, 50micrograms digested DNA : 50 undigested DNA : 450 digested DNA : 450 undigested DNA. In lanes 1 and 3 the smaller band has a size of about 1kB which corresponds to RBS-XylE gene. The bigger bands are the cut vectors. In lanes 2 and 4 is the uncut biobrick from the registry. It appears smaller on the gel than it actually is as circular DNA travels faster through the pores of agarose gel rather than linearised DNA.

Monday, 16-Aug-2010
- midi-preped the XylE-transformed E.coli. The DNA yeild from the midi-prep was 134micrograms as determined by spectrophotometry. This is the XylE that is going to be used for all further experiments.
- restriction digestion of midi-prepped XylE by Xbal and PstI to prepare it for 3A assemply. (with J23101 promoter and PSB1C3 vector)
- gel analysis of the restriction digestion mixture to isolate XylE gene

- I made an overnight culture of Bacillus
Tuesday, 17-Aug-2010
- using the Gel Extraction Kit, we isolated the restriction enzyme cut XylE gene from the agarose gel lamp.
- gel analysis of XylE, J23101 promoter and pSB1C3 vector samples to determine their ratios for 3A assemply ligation
- 3A assemply of XylE, J23101 promoter and pSB1C3 vector.
- Transformation of XL-Blue competent E.coli with the above construct.
*I followed Chris's Bacillus transformation protocol to transform Bacillus with constitutive GFP and RFP DNA as well as a control without DNA
Thursday, 19-Aug-2010
- We run the XylEGFP1 PCR reaction to construct the His-GFP-Flag and Linker-XylE-Spe construct.
Friday, 20-Aug-2010

- we run a gel on XylEGFP1 PCR reaction. Results: GFP was extended successfully, XylE extension FAILED (too much non-specific annealing)
- catechol assay on 2hrs bench ligation of promoter,xylE and vector failed.
- two replica plates of overnight ligated J23101, XylE and pSB1C3 transformed E.coli (one for catechol assay)
- the His-GFP-Flag DNA was gel purified
- transformation of XL-1Blue cells with J23101 in J62001 vector from the registry. One more attemp to construct a successful promoter-xylE ligation, since we believe that the strand annealed promoter was of bad quality
Monday, 23-Aug
- set up overnight cultures for midi-prep
- gel separation of linker-XylE-Spe DNA FAILED
- PCR reaction for extension of His-GFP-Flag
- Catechol assay on E.coli transformed with overnight ligated J23101, XylE and pSB1C3. FAILED
Tuesday, 24th-Aug
- midi-prepped registry obtained J23101. A yield of 130ng/ul of promoter was obtained. The promoter is in a biobrick vector called J62001. The promoter is upstream of RFP gene.
- the vector carrying the promoter was digested with SpeI and PstI, while XylE gene was digested with XbaI and PstI.
- the promoter and the XylE gene were gel purified.
- a reaction between the promoter(still on vector) and XylE was set on for overnight ligation
- PCR purification of GFP2 -> GFP construct ready for full fusion protein.
- Gel purification of XylE lost DNA along the way. Thus PCR XylE1 with gradient for temperature scanning (taq): PCR round 1 included 62C and only rev primer to create pool of successful extensions with with rev primer (60-62). PCR round 2 with Fwd primer and temperature scale (68-68, 72-74).
Wednesday, 25th-Aug
Performed gel analysis on the purified XylE and J23101 to obtain ratios for ligation. First gel was scrapped as it produced appauling(explanation for Nick:really bad) results, 2nd gel run was successful.
- Performed a ligation reaction between the vector containing J23101, and XylE(one on bench and one overnight one).
- Transformation of the new plasmid into competent E.coli. Successfully transformed colonies can be selected for by loss of RFP expression.
- XylE-1 PCR with temperature cascade. Gel analysis and purification.
Thursday, 26th-Aug
- white colonies from the promoter-XylE transformed E.coli were picked and transferred to new amp plates. One is the replica plate and the other is the catechol assay plate.
- XylE-1, two rounds of PCR/purification were run to obtain a sufficiently clear band. An additional PCR run for XylE-1 was discarded afterwards.
Friday, 27th-Aug
- Catechol assay performed on promoter-XylE transformed E.coli. SUCCESSFULL


- XylE-2 PCR and gel-purification cycles (2x) to obtain clear band. XylE-2 is now ready for assembly of the GFP-XylE fusion protein.
Saturday, 28th-Aug
- Preparing the annealing step between the GFP-2 and XylE-2 constructs, we discovered sequence dissimilarities in the TEV-cleavable regions which we planned to use for the annealing step. Nevertheless a PCR was run with appropriate conditions (allowing for a minimal amount of unspecific annealing).
Sunday, 29th-Aug
- Gel analysis of the attempted annealing reaction of GFP-2 XylE-2 showed unsufficiently clear bands for gel-purification. A new reaction is being prepared: 10 rounds of annealing PCR, followed by addition of primers (5' primer for GFP-2 and 3' primer for XylE-2) in order to introduce an amplification step in the reaction. --- Following Kirstins advice, we are discarding this reaction and wait for the arrival of new primers for XylE-2 (5' + TEV) and GFP-2 (3' +TEV).
Monday, 30th-Aug
- Mini prep of 4 x J23101-XylE taken from 4 different colonies (8 14 24 27).
- The gel analysis showed successful vector uptake.
- Set up an overnight culture for midi using colony 24 (gel analysis showed similar results colony 24 was picked randomly.)
Tuesday, 31st-Aug
- Midi prep of colony 24 for XylE-J23101 the final concentration was ~100ng/ul which wasnt so great but Chris says the protocol produces very poor yields.
- We are performing the next building step of our vector. PSB1C3 containing terminator B0014 was cut with EcoRI and XbaI. The insert was cut with EcoRI and SpeI and both were incubated for 1.5hrs. Wolf is now running a gel to purify out the insert via gel purification and perform a PCR purification on the vector.
- Advisors have decided it's best not to use Jeremy's tagged XylE due to the 93% difference. Kirsten will be tagging the registry XylE and we shall purify and assay with that instead.
- We shall see purification expert Kieran tomorrow and talk through the process. Chris will also talk us through our characterization of XylE experiments- we will use the robot after it's been programmed but until then we can use the plate-reader.
Thursday, 2nd-Sept

- Spectrophotometry experiments with XylE transformed E.coli in LB medium (M9 culture was contaminated) reveiled the followings: On catechol assay of the trasformed cells, the positive yellow output can be quantitively measured by a broad peak at 380nm.
- Trasformation of competent E.coli cells with promoter-XylE-terminator pSB1C3vector.
Friday, 3rd-Sept
- experiment to determine concentrations of catechol and cell density for assays

Output Photo Gallery